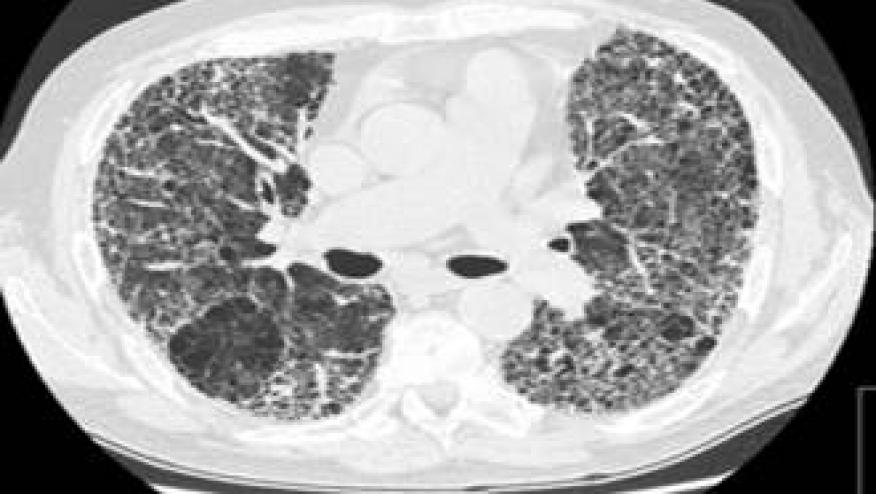

High-Resolution CT in CTD-Interstitial Lung Disease Save
A systematic review and meta-analysis examined the role of high-resolution computed tomography (HRCT) in diagnosing and characterizing interstitial lung disease (ILD) associated with connective tissue diseases (CTDs). The study analyzed 23 studies published between 2015-2024, encompassing 2020 patients with CTD-ILD across five major CTDs: systemic sclerosis (SSc), rheumatoid arthritis (RA), Sjögren's syndrome (SS), idiopathic inflammatory myopathies (IIMs), and mixed connective tissue disease (MCTD).
HRCT has emerged as the definitive gold standard in identifying and assessing ILD in CTD patients, offering several critical advantages, including Superior sensitivity, Early detection, Pattern recognition, and disease monitoring. HRCT distinguishes specific morphological patterns that correlate with prognosis and treatment response
Their analysis revealed distinct patterns across CTD-ILD cases:
- Non-specific interstitial pneumonia (NSIP): 36.5% (most common overall)
- Definite usual interstitial pneumonia (UIP): 24.8%
- Organizing pneumonia (OP): 9.8%
- Probable UIP: 3.48%
- Indeterminate UIP: 4.78%
- Lymphoid interstitial pneumonia (LIP): 1.25%
- Other patterns: 19.41%
When analyzing according to disease, specific patterns were identified:
- Systemic Sclerosis (SSc) - NSIP predominates (45-50% of cases)
- Characterized by ground-glass opacities, reticular changes, and lower lobe predominance
- Baseline HRCT recommended for all newly diagnosed SSc patients per 2024 guidelines
- Rheumatoid Arthritis (RA) - UIP is the most common pattern (approximately 45-60% of cases)
- Associated with significantly worse prognosis and threefold increase in mortality
- Risk-based HRCT screening recommended for high-risk patients (older males, smokers, high ACPA/RF titers)
- Distinctive CT signs help differentiate CTD-related UIP from idiopathic pulmonary fibrosis
- Sjögren's Syndrome (SS) - heterogeneous distribution with NSIP and LIP showing substantial representation
- LIP significantly more common in SS compared to other CTDs
- Idiopathic Inflammatory Myopathies (IIMs) - NSIP most frequent (approximately 40-50%)
- OP pattern also common (about 20%)
- MCTD - NSIP predominant pattern
- ILD prevalence ranges from 27.4% to 78%
HRCT patterns carry significant prognostic value:
- UIP pattern: Associated with poor prognosis, accelerated decline, and higher mortality
- NSIP pattern: Generally more favorable prognosis with better treatment response
- OP pattern: Excellent corticosteroid responsiveness and favorable outcomes
- LIP pattern: May progress to lymphoproliferative disorders, requiring careful monitoring
Clinical Practice Implications: These findings support current guidelines recommending baseline HRCT for all newly diagnosed SSc patients, while advocating for risk-based screening in other CTDs. The ability to identify specific patterns (UIP, NSIP, OP, LIP) enables clinicians to predict outcomes and tailor treatment approaches.
The synopsis demonstrates how HRCT has evolved from a supplementary tool to the gold standard for CTD-ILD assessment, fundamentally changing how clinicians approach early detection, prognostic stratification, and treatment planning in these complex autoimmune conditions. While NSIP emerges as the most common pattern overall, disease-specific variations highlight the importance of integrating radiological findings with clinical context. The study reinforces current guidelines recommending baseline HRCT for high-risk CTD patients and emphasizes the need for standardized, disease-specific monitoring protocols to optimize patient outcomes.










If you are a health practitioner, you may Login/Register to comment.
Due to the nature of these comment forums, only health practitioners are allowed to comment at this time.